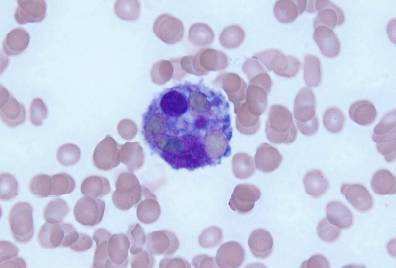
噬血細胞綜合征

噬血細胞綜合征簡介:
噬血細胞綜合征(HLH)被認為是一種單核巨噬系統(tǒng)反應(yīng)性增生的組織細胞病���,主要是由于細胞毒殺傷細胞(CTL)及NK細胞功能缺陷導(dǎo)致抗原清除障礙�����,單核巨噬系統(tǒng)接受持續(xù)抗原刺激而過度活化增殖�,產(chǎn)生大量炎癥細胞因子而導(dǎo)致的一組臨床綜合征���。噬血細胞綜合征主要表現(xiàn)為發(fā)熱��、脾大��、全血細胞減少���、高甘油三酯、低纖維蛋白原�����、高血清鐵蛋白,并可在骨髓��、脾臟或淋巴結(jié)活檢中發(fā)現(xiàn)噬血現(xiàn)象����。